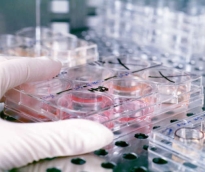
alsharq

قالت قطر للطاقة إن مدينة راس لفان الصناعية تعرضت هذا المساء لهجمات صاروخية. وأوضحت أنه تم على الفور نشر فرق الاستجابة للطوارئ لاحتواء...
رئيس مجلس الإدارة : د. خالد بن ثاني آل ثاني

رئيس التحرير: جابر سالم الحرمي

مساحة إعلانية

كشفت التجارب الطبية عن نقص شديد في أدوية معالجة مرض الزهايمر، وأن 99.6 % من محاولات تطوير علاج جديد تبوء بالفشل. قام أطباء من مركز كليفلاند الطبي لعلاج المخ بتجارب، وأجروا أول تحليل من نوعه على الإطلاق لعلاجات الزهايمر، وكشفت نتائج التحليلات عن حاجة الطب الماسة لتطوير المواد الفعالة التي تدخل في تركيب الأدوية المستخدمة للعلاج، وكشفت أيضا عن الحاجة الماسة لزيادة عدد الأدوية. وأوضحت نتائج البحوث أن معدلات فشل تطوير علاجات جديدة للمرض بلغت 99.6% خلال العقد من 2002–2012، وأن عدد الأدوية المتاحة لعلاج المرض تناقص منذ عام 2009، ويقدر الأطباء عدد المصابين بالمرض حول العالم بـ 44 مليون مريض. وأكدت البحوث أن الاستثمارات في مجال أدوية الزهايمر لا تزال قليلة، إذا ما قورنت بأمراض أخرى مثل السرطان والأزمات القلبية، بالرغم من المخاطر والمشاكل الكبيرة التي يسببها المرض. ومن أجل الإسراع في عملية تطوير عقاقير الزهايمر أوصى الأطباء بضرورة مواصلة دراسة الأدوية المتاحة حاليا والمسموح بتداولها، والكشف عن إمكانية إعادة إنتاجها مع إدخال عناصر ومركبات فعالة، تؤدي لنتائج أفضل في العلاج.
550
| 06 يوليو 2014

قال علماء من أمريكا، إنهم عثروا على تفسير محتمل لوجود مسارات مختلفة لمرض ألتسهايمر "الزهايمر" مما يصعب تطوير عقاقير مناسبة للتداوي منه. وحسب الباحثين تحت إشراف ستانلي بروسينر من جامعة كاليفورنيا، بمدينة سان فرانسيسكو، في دراستهم التي نشرت نتائجها، اليوم الثلاثاء، في مجلة "بروسيدنجز" التابعة للأكاديمية الأمريكية للعلوم، فإن هناك على الأقل سلالتين مختلفتين للبروتين الذي يؤدي للإصابة بالمرض. يشار إلى أن الطبيب بروسينر حصل عام 1997 على جائزة نوبل للطب على اكتشافه ما يسمى بالبريونات. ومشيرا لنتائج الدراسة قال بروسينر"يمكن أن تساعد النتائج التي توصلنا إليها في شرح كيفية نشأة مرض ألتسهايمر على مستوى الجزيئات وتطوير عقاقير مضادة لبريونات أميلويد بيتا". ومن المعروف أن أميلويد بيتا هو بروتين ينشأ خلال عملية الأيض ولكنه عادة ما يتحلل، وتتراكم أحماض أميلويد بيتا المصابة بكميات كبيرة في المخ وتدمر الخلايا العصبية بشكل تدريجي وناقل لعدوى الأحماض المصابة، مما يجعل الإصابات تنتقل لأحماض أميلويد بيتا السليمة، حسبما أكد الباحثون.
262
| 01 يوليو 2014

كشفت دراسة أمريكية حديثة، أن الكاكاو يعد وسيلة آمنة للوقاية من مرض الزهايمر، لأنه يمنع تراكم البروتينات الضارة التي تسبب تلف الدماغ، لاحتوائه على مركب البوليفينول المضاد للأكسدة. وأوضح الباحثون، بكلية الطب في جامعة "إيكان جبل سيناء"، في مدينة نيويورك، في دراستهم التي نشروا تفاصيلها، أمس الإثنين، في "مجلة مرض الزهايمر" العلمية، أنهم استخدموا الفئران المعدلة وراثياً لمحاكاة الإصابة بمرض الزهايمر، ووجدوا أن الكاكاو يمنع تراكم بروتينات "beta-amyloid"، الذي يشكل كتلا لزجة بالدماغ، تؤدى إلى تلف الخلايا العصبية، خاصة مع تقدم مرض الزهايمر. وأشاروا إلى أن، الزهايمر من الأمراض التي تدمر الذاكرة وقدرات التفكير، ويعتبر تراكم بروتينات "beta-amyloid" بالمخ من أهم علاماته، حيث تقوم هذه التراكمات بتدمير الخلايا العصبية، الأمر الذي يؤدي لاختلال القدرات المعرفية و فقدان الذاكرة. وتُشير الأبحاث إلى أن هناك صلة وثيقة بين تناول الكاكاو الخام، وتحسين وظائف المخ، وخاصة بين كبار السن، ويرجع ذلك إلى وجود مادة الفلافينويد في الكاكاو الخام التي تعمل على زيادة تدفق الدم في المخ، مما يؤدي إلى تحسين أداء المخ وزيادة اليقظة والتنبية.
512
| 24 يونيو 2014

"يا بني، أنا أخذت الدواء منذ نصف ساعة".. كانت هذه هي الجملة التي يسمعها المصري خالد جمال الدين، الباحث في المركز القومي للبحوث من جده لأبيه، كلما عرض عليه الدواء، رغم أنه لم يكن قد تناوله. ظل هذا الموقف اليومي الذي عايشه جمال الدين حاضرًا في ذهنه، ليشكل واحدًا من أهم أمنياته مستقبلاً، وهو إنتاج دواء لعلاج مرض "الزهايمر". وهي الأمنية التي اقترب كثيرا من تحقيقها، لعلاج المرض الذي يصيب شخصًا في العالم كل أربع ثوان، ومن المتوقع أن يصل عدد المصابين به إلى 38 مليون شخص مع نهاية العام الجاري. جمال الدين، الذي كان يجري تجارب على عشب طبيعي هو "الروزماري" لاستخلاص مواد منه تساهم في تخفيف الآثار الجانبية لاستخدام المواد الكيماوية في علاج الأورام السرطانية، اكتشف أن من بين أهم محتويات هذا العشب هي مواد لها نشاط مضاد للأكسدة، فكان ذلك هو الخيط الذي قرر أن يسير خلفه وصولاً إلى تحقيق أمنيته في التوصل إلى علاج لمرض الزهايمر. ومضى قائلا: "من المعروف علميًا أن المواد التي لها نشاط مضاد للأكسدة مفيدة بشكل عام في مقاومة الشيخوخة وتقدم السن، فكان التفكير في استخدامها كعلاج لمرض الزهايمر". ومثل أي بحث علمي، أجرى جمال الدين التجربة أولاً على حيوانات التجارب، تمهيدًا للانتقال إلى متطوعين من المرضى، وكانت النتائج التي أجريت على فئران تجارب "إيجابية" للغاية، على حد قوله. وأضاف جمال الدين: "أعطيت فئران التجارب موادا تسبب مرض الزهايمر، ثم درست الأعراض التي يحدثها المرض بقشرة المخ والدم، فثبت أن هذه الحالة يصحبها أعراض تصيب القشرة، منها زيادة كبيرة في مستوى أكسدة الدهون، يصاحب ذلك ارتفاع في مستوى أكسيد النتريك والكالسيوم والبولينا والكرياتينين في الدم".
495
| 09 فبراير 2014

يعتقد باحثون أمريكيون أن استخدام المبيدات الحشرية التي تحتوي على مركب "دي دي تي" قد تعزز الإصابة بمرض الزهايمر. وأظهرت دراسة نشرتها دورية "جاما"، المعنية بعلم الأعصاب، أن نسبة وجود مركب "دي دي تي" في أجسام المرضى المصابين بالزهايمر تسجل أربعة أضعاف النسب المرصودة لدى الأصحاء. ولكن مركز أبحاث الزهايمر ببريطانيا أكد أنه لا زالت هناك حاجة إلى توفير أدلة علمية أكثر لإثبات وجود علاقة بين استخدام المبيدات الحشرية التي تحتوي على المركب والإصابة بهذا المرض. ولا زالت بعض الدول تستخدم المركب في عمليات مكافحة مرض الملاريا، حيث أثبت كفاءة عالية في القضاء على هذا المرض منذ استخدامه في أعقاب الحرب العالمية الثانية، فضلا عن فعاليته في حماية المحاصيل التجارية. كان فريقا بحث من جامعتي روتجرز وإيموري قد أجريا اختبارا لمركب "دي دي إي" في عينات دم أُخذت من 86 مريضًا بالزهايمر ومقارنة النتائج بعينات أُخذت من 79 شخصا من الأصحاء من نفس الأعمار والخلفيات. وتوصل الباحثون إلى أن أجسام المرضى تحتوى على نسبة "دي دي إي" تصل إلى 3.8 ضعف النسبة لدى الأشخاص العاديين.
416
| 28 يناير 2014

بينت دراسة أمريكية، أن المرضى الذين يحملون مستويات عالية من الكولسترول "الضار" في الدم، لديهم مستويات ضارة من بروتين داخل أدمغتهم. وتسمى تلك العناصر، "لويحات بيتا أميلويد"، وهـي واحدة من العلامات الرئيسة لمرض "الزهايمر"، ويعتقد أنها تؤثر على طريقة عمل خلايا الدماغ. وقد أشارت دراسة أخرى، أن تقليل كمية الكولسترول السيئ وزيادة الكولسترول الجيد، الذي يتناوله المرء قد يساعد على الحد من مخاطر مرض الزهايمر. ووفقاً لصحيفة "إندبندنت" البريطانية، يوصي الأطباء الناس، بالفعل، بتقليل كمية استهلاك الكولسترول الضار، وزيادة الكولسترول الجيد نظراً لأثر ذلك على أمراض القلب والدماغ.
399
| 22 يناير 2014
توصلت شركة روش السويسرية للمستحضرات الطبية لطريقة ناجعة تمكن أدوية تستخدم الأجسام المضادة من الوصول إلى المخ واختراقه وهو ما يفتح باب الأمل في التوصل إلى علاجات فعالة لأمراض منها الزهايمر. وأجريت التجارب على تكنولوجيا مكوك المخ المستحدثة على الفئران فقط وهي تسمح بتخطي الحاجز الدموي الدماغي الذي يفصل بين الدم وسائل خارج الخلية الدماغية في الجهاز العصبي المركزي وهو ما كان يشكل عقبة في أبحاث الأدوية الخاصة بالأعصاب لان هذا الحاجز كان يغلق الباب في وجه جزيئات كبيرة مثل الأجسام المضادة ويمنعها من الوصول الى المخ. ومرض الزهايمر هو مرض قاتل يقضي على وظائف المخ وأصاب 44 مليون شخص على مستوى العالم وتتوقع الجمعية الدولية لمكافحة الزهايمر أن عدد المصابين بالمرض سيزيد لثلاثة أمثاله بحلول عام 2050. وعلى الرغم من انه لا يوجد حتى الآن علاج من المرض بشكل فعال أو دواء لإبطائه تجري عدد من الشركات منها روش وإيلي ليلي وميرك آند كو وجونسون آند جونسون أبحاثا للوصول إلى أصل المرض. وثبت أن هذه المعركة ليست سهلة. فعلى مدى 15 عاما فشل أكثر من مئة دواء تجريبي للزايمر في مراحل الاختبار. لكن محللي الصناعة يعتقدون ان العائد سيكون مجزيا في حالة التوصل إلى علاج حقيقي للمرض وقدروا سوق المبيعات بنحو عشرة مليارات دولار في العام. وتعمل التكنولوجيا المستحدثة لروش باختطاف آلية نقل طبيعية يستخدمها جسم الإنسان بشكل طبيعي لنقل البروتينات داخل المخ. وقال لوكا سنتاريلي رئيس قسم علوم الأعصاب وأمراض العيون والإمراض النادرة في روش خلال اتصال هاتفي "صممنا في الأساس هذه المركبة التي أطلق عليها اسم المكوك التي تلتحم مع آلية النقل هذه وتنقل شحنة إلى المخ". وخلصت نتائج الدراسة التي نشرت أمس الأربعاء في دورية "نيورون" إلى أن هذه لتكنولوجيا ساعدت على زيادة تركيز الأجسام المضادة في أدمغة فئران التجارب وأنها خفضت حجم الصفائح النشوية التي تعد علامة أكيدة على الإصابة بالزهايمر.
317
| 09 يناير 2014

أظهرت دراسة جديدة، أن تناول جرعات يومية كبيرة من الفيتامين "إي"، قد يساعد على إبطاء مرض الزهايمر. ونقل موقع "هلث دي نيوز" الأمريكي، عن الباحث المسؤول عن الدراسة في جهاز "مينيابوليس في أي" للرعاية الصحية، موريس ديسكن، أن مرضى الزهايمر الذين أعطوا جرعات دوائية من الفيتامين "إي"، سجّلوا تباطؤا في تراجع التفكير والذاكرة، وتطلبوا رعاية أقل ممن أخذوا دواء وهمياً. وأضاف "ديسكن"، وجدنا أن الفيتامين "إي"، أبطأ بشكل ملحوظ معدّل تقدّم المرض، لكن الخبراء شددوا على أن هذا الفيتامين لا يبدو أنه يكافح السبب الكامن وراء المرض، وهو ليس وسيلة للشفاء. وشملت الدراسة، ما يزيد عن 600 مريض في 14 مركزا طبيا، وقسّم المرضى إلى مجموعات تلقت كل منها علاجاً مختلفاً. وتناول ربع المرضى جرعة يومية مقدارها 2000 وحدة دولية، "IU" من توكوفيرول، وهو نوع من فيتامين "إي"، وهي جرعة كبيرة نسبياً مقارنة بالجرعات اليومية من الفيتامينات المتعددة التي تحتوي على 100 وحدة دولية من الفيتامين "إي". وأعطيت المجموعات الأخرى من المرضى علاج الميمانتين، ومزيجاً من الفيتامين إي" والميمانتين ، وعلاجاً وهمياً. وتبيّن أن الأشخاص الذين تناولوا جرعات الفيتامين وحدها خلال الدراسة التي تواصلت على مدى عامين وخمسة أشهر قل لديهم تقدم المرض بمعدل 19 % مقارنة بمن تناولوا دواء وهمياً.
364
| 01 يناير 2014
مساحة إعلانية
الأكثر مشاهدة

أعلنت الخطوط الجوية القطرية الاستمرار بتعليق رحلاتها مؤقتاً مع تشغيل عدد محدود من الرحلات الجوية في الفترة الممتدة من 18 - 28 مارس...
19582
| 16 مارس 2026

قالت وزارة الأوقاف والشؤون الإسلامية إنه في ظل الظروف الراهنة التي تمر بها الدولة، وحفاظاً على سلامة المصلين، فقد تقرر عدم إقامة صلاة...
12588
| 17 مارس 2026

أعلنمطار حمد الدولي، انسحابه من جميع المعارض الخارجية، والمؤتمرات، والفعاليات الخاصة بقطاع المطارات وبرامج الجوائز خلال هذه الفترة. وقال مطار حمد في بيان...
12084
| 17 مارس 2026

حمل تطبيق الشرق
تابع الأخبار المحلية والعالمية من خلال تطبيقات الجوال المتاحة على متجر جوجل ومتجر آبل
الأكثر رواجاً
- 1 وزارة الداخلية: إقامة المناسبات وحفلات الزواج ومجالس العزاء بالقاعات والأماكن المغلقة فقط
في إطار الحرص على السلامة العامة، تهيب وزارة الداخلية القطرية بالجميع التقيد بالإجراءات الاحترازية عند إقامة المناسبات الاجتماعية، بما في ذلك حفلات الزواج...
10730
| 18 مارس 2026
- 2 للمقيم في قطر.. هل يجوز إخراج زكاة الفطر في بلده الأصلي؟.. الشيخ موافي عزب يُجيب
مع اقتراب نهاية شهر رمضان المبارك، يزداد تساؤل المقيمين في دولة قطر وفي غيرها من الدول التي تستقطب الوافدين حول كيفية إخراج زكاة...
9824
| 16 مارس 2026
- 3 د. الأنصاري يوضح تفاصيل إطلاق صاروخ إيراني على مجمع سكني في قطر واعتراضه
قال الدكتور ماجد بن محمد الأنصاري مستشار رئيس مجلس الوزراء المتحدث الرسمي لوزارة الخارجية إن الهجمات الإيرانية على دولة قطر لا تزال مستمرة،...
8704
| 16 مارس 2026



